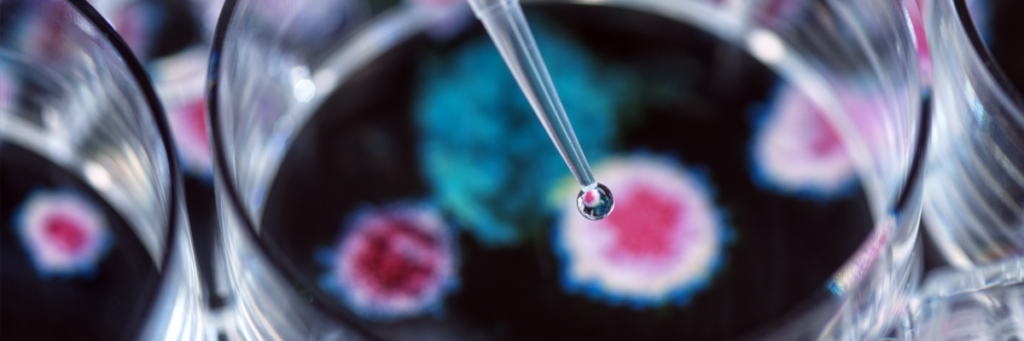

España consolida su liderazgo europeo en investigación clínica
- Julio García
- Categories: Sociedad
- Tags: AEMPSensayos clínicosinvestigación
Contenido relacionado
La inversión de Europa en medicamentos innovadores genera un retorno de hasta seis veces su coste
Por
Julio García
23/06/2026
Diez años después: el Brexit y la irresponsabilidad de las mayorías mínimas
Por
Xabier González Barkos
23/06/2026
La UE registró 669.710 solicitudes de asilo por primera vez en 2025
Por
Adriana Piñeiro
19/06/2026
Pollença, Vanuatu o Cibeles de Cine, planes de ‘Selección Fin de Semana’
Por
Redacción Aquí Europa
19/06/2026
